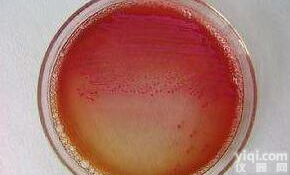
CMCC 44102 <em>冻干</em>粉  <em>大肠</em>埃希氏菌

ATCC25922大肠埃希氏菌 标准菌株 冻干
- 型号:ATCC25922
- 产地:中国大陆
- 供应商:北京普天同创生物科技有限公司
- 供应商报价:电议
- 标签:ATCC25922大肠埃希氏菌 标准菌株 冻干,生物试剂,标准物质,供应ATCC25922大肠埃希氏菌 标准菌株 冻干,北京普天同创生物科技有限公司
经营范围:国家标准物质、进口标准品、冶金标样、标准气体、药典对照品、标准菌种、实验室耗材、试剂盒、抗体
产品信息: ATCC25922大肠埃希氏菌 标准菌株 冻干
| ATCC® Number: | 25922™ |
| Organism: | Escherichia coli (Migula) Castellani and Chalmers |
| Designations: | FDA strain Seattle 1946 [DSM 1103, NCIB 12210] |
| Isolation: | clinical isolate |
| Depositor: | FDA |
| History: | ATCC <<--FDA<<--F. Schoenknecht |
| Biosafety Level: | 1 |
| Shipped: | freeze-dried |
| Growth Conditions: | ATCC medium18: Trypticase soy agar Temperature: 37.0°C Atmosphere: Aerobic |
| Permits/Forms: | In addition to the MTA mentioned above, other ATCC and/or regulatory permits may be required for the transfer of this ATCC material. Anyone purchasing ATCC material is ultimately responsible for obtaining the permits. Please click here for information regarding the specific requirements for shipment to your location. |
| Cross References: | Nucleotide (GenBank) : AF038431 Escherichia coli DNA gyrase A (gyrA) gene, partial cds. Nucleotide (GenBank) : AX110212 Sequence 945 from Patent WO0123604. Nucleotide (GenBank) : AX110242 Sequence 975 from Patent WO0123604. Nucleotide (GenBank) : AX111547 Sequence 2280 from Patent WO0123604. Nucleotide (GenBank) : X80724 E. coli (ATCC 25922) gene for 16S rRNA. |
| Comments: | Incorrectly cited in previous editions of this catalog as identical to NCTC 10418 |
另外,我们提供各种不同浓度的单标及混标定制服务,包含【十一大系列】(真诚合作,诚招代理):
· 中药对照品
· 分析滴定液
· 指示剂溶液
· 标准气体
· 农残类标准溶液
· 水质检测标准溶液
· TOC/TIC标准液
· 原子吸收光谱仪标准液
· PH缓冲液(PH校正液@25℃)
· 比色计专用标准液(铂钴比色标准液)
· 离子层标准液(阴离子标准液、阳离子标准液)
公司简介:
ZG标准物质网隶属于北京普天同创生物科技有限公司,是国内的专业化标准物质信息平台。创建以来,一直专注于标准物质的推广与销售,是多家知名标准物质研制单位和分析仪器公司的代理商,代理销售国内外数万种标准物质和标准样品,同时经营各类精细化工产品及计量设备,业务遍及国内外众多检测机构、科研院校和工厂企业,在业界具有较强的影响力。
![优质金黄色葡萄球菌(敏感<em>菌株</em>)[ATCC25923]/<em>冻干</em>粉 标准质控<em>菌株</em>](https://item.yiqi.com/pic/CovPic/4/3273940983662177140-14.jpg)

![<em>大肠</em>埃希氏菌[ATCC25922] <em>冻干</em>粉 专业生产标准指控<em>菌株</em>](https://item.yiqi.com/pic/CovPic/4/3273906561646933838-14.jpg)



